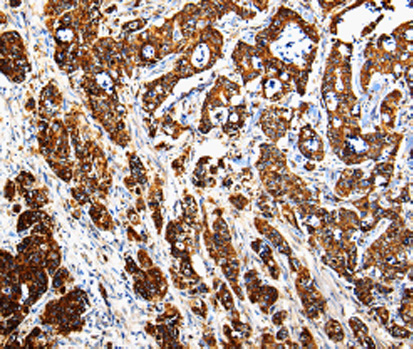
A2678: image 2

For quotations, please use our online quotation form, and you may also contact us by
service@kendallscientific.com
+1-888.733.6849 (Toll-free)
+1-617.299.7367 (Int’l))
+1-888.733.6849
Our customer service representatives are available 24 hours, Monday through Friday to assist you.| Reactivity | Human Mouse Rat |
| Tested applications | WB IHC IF |
| Recommended Dilution | WB 1:500 - 1:2000 IHC 1:50 - 1:200 IF 1:50 - 1:200 |
| Calculated MW | 43kDa |
| Observed MW | Refer to Figures |
| Immunogen | Recombinant protein of human CTSE |
| Storage Buffer | Store at -20℃. Avoid freeze / thaw cycles. Buffer: PBS with 0.02% sodium azide, 50% glycerol, pH7.3. |
| Synonym | CATE; |

Western blot analysis of extracts of various tissues, using CTSE antibody.
Immunohistochemistry of paraffin-embedded human pancreatic cancer tissue using CTSE antibody.

Immunohistochemistry of paraffin-embedded human stomach cancer using CTSE antibody at dilution of 1:200 (400x lens).

Immunofluorescence analysis of MCF-7 cell using CTSE antibody.
The protein encoded by this gene is a gastric aspartyl protease that functions as a disulfide-linked homodimer. This protease, which is a member of the peptidase C1 family, has a specificity similar to that of pepsin A and cathepsin D. It is an intracellular proteinase that does not appear to be involved in the digestion of dietary protein and is found in highest concentration in the surface of epithelial mucus-producing cells of the stomach. It is the first aspartic proteinase expressed in the fetal stomach and is found in more than half of gastric cancers. It appears, therefore, to be an oncofetal antigen. Transcript variants utilizing alternative polyadenylation signals and two transcript variants encoding different isoforms exist for this gene. [provided by RefSeq, Jul 2008]
N/A